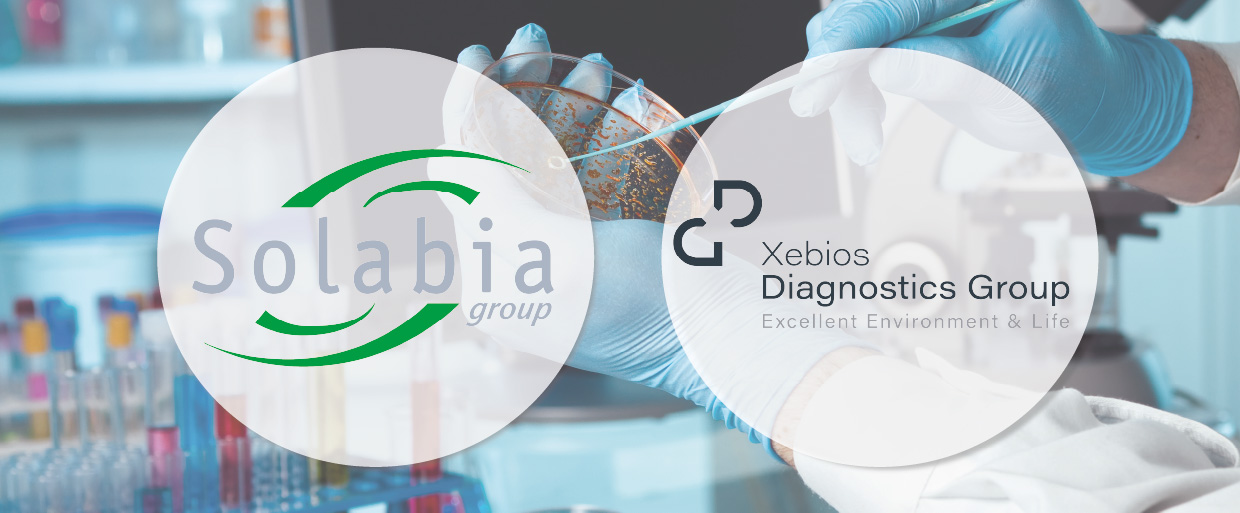

|
프랑스의 글로벌 뷰티‧헬스 원료 분야 리더기업 솔라비아 그룹(Solabia Group)의 기업 인수‧합병(M&A) 릴레이가 이어지고 있어 주목할 만해 보인다.
솔라비아 그룹은 독일의 진단 미생물학 솔루션 리더기업 제비오스 다이어그노스틱스 그룹(Xebios Diagnostics Group)을 인수한다고 5일 공표했다.
여기서 그치지 않고 솔라비아 그룹은 프랑스 시퀀스(Seqens)의 식물성 활성성분 및 체외진단(IVD) 사업부문을 인수한다고 같은 날 공표했다.
앞서 솔라비아 그룹은 화장품업계 뿐 아니라 기능식품업계와 식품업계를 위해 고효능의 차별화된 원료 개발‧제조를 진행하는 데 특화된 기업으로 낯설지 않은 스위스(瑞西) 혁신기업 미벨 바이오케미스트리(Mibelle Biochemistry)를 인수한다고 지난달 19일 공개한 바 있다.
제비오스 다이어그노스틱스 그룹은 독일과 네덜란드를 비롯한 서유럽 각국의 화장품, 식품, 음료 및 음용수 시장에서 분석을 진행하기 위한 진단용 배지(culture media: 미생물, 세포, 조직 등을 실험실에서 증식, 배양하기 위해 필수적인 영양소들을 혼합해 만든 영양물질) 및 시약 분야에서 강력한 명성을 구축한 기업으로 알려진 곳이다.
솔라비아 그룹은 제비오스 다이어그노스틱스 그룹을 인수함에 따라 유럽 내 진단시장에서 자사의 존재감을 크게 강화하면서 확대할 수 있게 됐다.
이미 식품검사 분야에서 글로벌 기업으로 확고한 입지를 다진 솔라비아 그룹이 글로벌 마켓 도달과 기술적 전문성 등에서 고도의 보완성을 내포하고 있는 파트너라 할 수 있는 제비오스 다이어그노스틱스 그룹을 인수하면서 자사의 역량을 크게 확충할 수 있게 되었기 때문.
실제로 제비오스 다이어그노스틱스 그룹을 인수함에 따라 솔라비아 그룹은 독일, 프랑스 및 네덜란드 등에서 자사의 제조기반을 크게 강화하고, 혁신역량을 향상시키면서 고효능 미생물 솔루션 제품들로 고객기업들에게 서비스를 제공할 수 있는 능력 또한 괄목할 만하게 개선할 수 있게 됐다.
솔라비아 그룹의 장-밥티스트 들롱 대표는 “제비오스 다이어그노스틱스 그룹이 솔라비아 그룹의 일원으로 동승하게 된 것을 환영해 마지 않는다”면서 “인수가 성사됨에 따라 유럽시장에서 진단 분야의 선도적인 플랫폼을 구축하고자 하는 우리의 야망에 크게 힘이 실리게 되었기 때문”이라고 말했다.
우리가 보유한 노하우와 산업적 역량, 글로벌 마켓 진출범위, 상호보완적인 제품 포트폴리오 등이 결합되면서 한층 더 강력하고 고객기업들에게 폭넓게 다가서면서 높은 잠재력을 내포하고 있는 여러 시장에서 우리의 성장이 가속화될 수 있을 것이라고 덧붙이기도 했다.
제비오스 다이어그노스틱스 그룹의 크리스토프 멘첼 대표는 “솔라비아 그룹과 팀을 이루게 됨에 따라 제비오스 다이어그노스틱스 그룹에 강력하고 새로운 장(章)이 펼쳐질 수 있게 됐다”면서 “품질, 혁신 및 고객 중심을 통해 성공 스토리를 써내려 온 우리에게 솔라비아 그룹은 그 같은 강점을 강화하기 위한 최적의 파트너라 할 수 있을 것”이라고 강조했다.
솔라비아 그룹의 깊이있는 산업역량과 보완적인 전문성, 장기적인 비전이 우리가 혁신을 가속화하고, 글로벌 마켓 진출범위를 확대하고, 고객기업들에게 보다 임팩트 있는 솔루션을 제공해 줄 수 있도록 해 줄 것이라고 멘첼 대표는 단언하기도 했다.
한편 솔라비아 그룹은 프랑스의 의약품‧화장품 원료, 중간체 및 특수원료 전문기업 시퀀스로부터 식물성 활성성분 부문 및 체외진단 사업부문을 인수한다고 같은 날 공표함에 따라 화장품용 식물성 활성성분들과 진단용 혈장시료 등을 개발하고 제조할 수 있는 역량을 크게 끌어올릴 수 있게 됐다.
프랑스 중남부 도시 리모주에 소재한 시퀀스의 식물성 활성성분 부문 및 체외진단 사업부문은 첨단 식물 추출물과 고효능 제조 역량으로 잘 알려져 왔다.
두 분야에서 글로벌 리딩 브랜드들이 시퀀스의 다양한 식물성 활성성분과 체외진단 솔루션 제품들을 활발하게 사용해 왔을 정도.
인수를 성사시킴에 따라 솔라비아 그룹은 화장품용 식물성 활성성분 부문에서 글로벌 리딩 공급업체로 자리매김할 수 있게 된 데다 진단용 원료 분야에서도 탄탄한 입지를 구축할 수 있게 됐다.
솔라비아 그룹은 두 분야에서 이미 강력하고 활발하게 사업을 전개해 오면서 장기적인 성장을 도모해 왔다.
솔라비아 그룹의 장-밥티스트 들롱 대표는 “시퀀스의 식물성 활성성분 부문과 체외진단 조직이 솔라비아 그룹의 일원으로 동승하게 된 것을 기쁘게 받아들인다”면서 “우리 또한 핵심적인 사업의 하나로 같은 분야에서 경영을 이어온 만큼 고도의 상호보완적인 성과를 기대할 수 있게 되었기 때문”이라고 말했다.
양사의 역량이 결합되면서 시장에서 솔라비아 그룹의 지위가 크게 강화되면서 공급망을 더욱 탄탄하게 하고, 고객들에게 보다 견고하고 혁신적인 솔루션을 제공할 수 있게 될 것이라고 들롱 대표는 단언했다.
강력한 성장 잠재력을 내포하고 있는 시장에서 우리가 전개하고 있는 사업이 지속적으로 강화될 수 있을 것이라고 덧붙이기도 했다.
시퀀스의 파스칼 빌마뉴 대표는 “이번 합의가 우리의 장기적인 전략적 비전에 완벽하게 부합되는 것”이라면서 “덕분에 시퀀스는 핵심적이고 우선순위가 높은 사업영역들에 한층 더 초점을 맞출 수 있게 됐다”고 말했다.
리모주에서 재직해 온 조직의 경우 더욱 활발한 활동을 전개하면서 성장목표를 이행해 나갈 수 있게 될 것이라고 빌마뉴 대표는 전망했다.
연이은 M&A를 통해 사업역량을 배가하고 있는 솔라비아 그룹의 차후 행보를 지켜볼 일이다.
-
01 [기고] 리니칼, 연구에 적합한 CRO 선택하기... -
02 툴젠과 오가노이드사이언스의 이유 있는 동거 -
03 성인까지 치료 문 열렸지만…NF1 치료 접근성... -
04 미국, 임신 중 아세트아미노펜 ↓ vs. 류코보... -
05 "밖으론 포성, 안으론 정책 칼바람"… 최악의... -
06 LG화학, 작년 영업익 16% 껑충…미국 아베오 ... -
07 일본 여성 절반은 ‘의무감’으로 스킨케어 -
08 유전자 치료제 시장 '확장 국면'…에스티팜·... -
09 메지온 'JURVIGO', 폰탄치료제 FDA-유럽 승... -
10 동성제약, ‘회생 부결설’ 정면 반박…“1600억...











